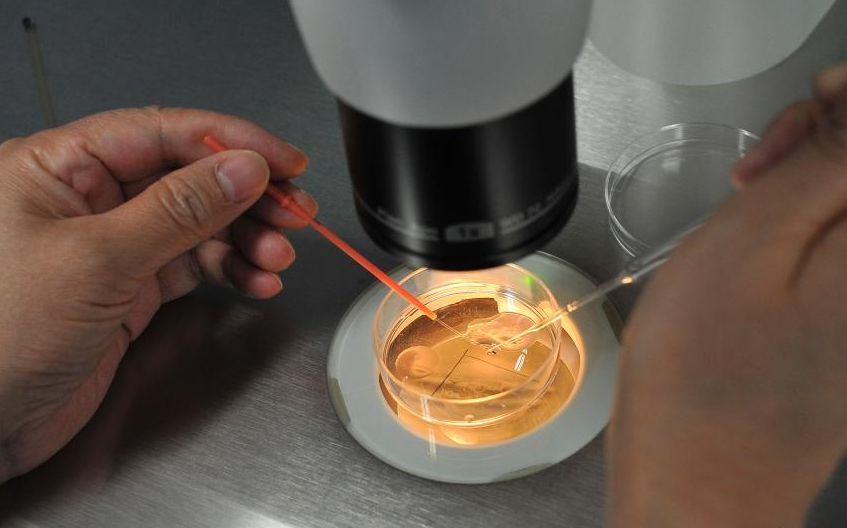

苏州供精试管婴儿医院推荐
苏州供精试管婴儿医院推荐苏州作为江南名城,医疗技术发达,拥有多家实力雄厚的供精试管婴儿医院,为想要生育的家庭提供优质的服务。 如果您正在考虑进行供精试管婴儿,以下是一些值得关注的医院:
南京妇产医院南京妇产医院是江苏省最早开展人工授精和体外受精技术的医疗机构之一,拥有丰富的临床经验和强大的专家团队。 医院拥有一流的诊疗设备和先进的技术,能够为患者提供全方位、一体化的服务,涵盖试管婴儿助孕、遗传咨询、胚胎移植等多种项目。
苏州大学附属第二人民医院苏州大学附属第二人民医院是一家集医疗、教学、科研三位一体的综合性三级甲等医院,拥有先进的医疗设备和资深的专家团队。医院在辅助生殖技术方面具有领先优势,提供专业的供精试管婴儿服务,并注重患者的心理关怀和个性化治疗方案。
费用流程及试管移植过程供精试管婴儿的费用主要包括:卵子取出费用、胚胎培养费用、移植费用、药物费用等。 具体价格根据医院、地区、患者情况有所差异。
详细费用流程:1. 咨询与检查费:约为300元,包括医生咨询、基础体检、遗传咨询等费用。
2. 激发卵子药物费用:约为8500元,根据患者情况调整用药方案和周期,具体费用需根据医院收费标准。
3. 取卵手术费用:约为6000元,包含麻醉、手术等相关费用。
4. 胚胎培养费用:约为12000元,包括培养基、检测等费用。
5. 试管移植手术费用:约为5000元,包含麻醉、手术等相关费用。
6. 宫颈内膜厚度监测费用:约为1500元,根据患者情况安排监测次数,具体费用需根据医院收费标准。
试管移植过程胚胎移植手术时间短,一般在几分钟内完成。 医生将优质胚胎通过阴道镜放入子宫腔内,并用药物帮助受精卵着床和发育。 整个过程较为轻松,患者不需要忍受太大的痛苦。
温馨提示:上述费用仅供参考,具体收费标准请咨询医院工作人员。
关于试管成功率苏州供精试管婴儿医院的成功率一般在50%-65%之间,具体取决于患者的身体状况、胚胎质量以及医生的操作水平等因素。
结语选择一家合适的供精试管婴儿医院是开启生育之路的重要一步。希望以上信息能帮助您了解苏州的供精试管婴儿医院情况,以便做出更明智的选择。 记住,无论最终选择哪家医院,都要认真咨询医生,了解具体流程和费用,并做好心理准备,迎接美好的人生新篇章!


还没有内容